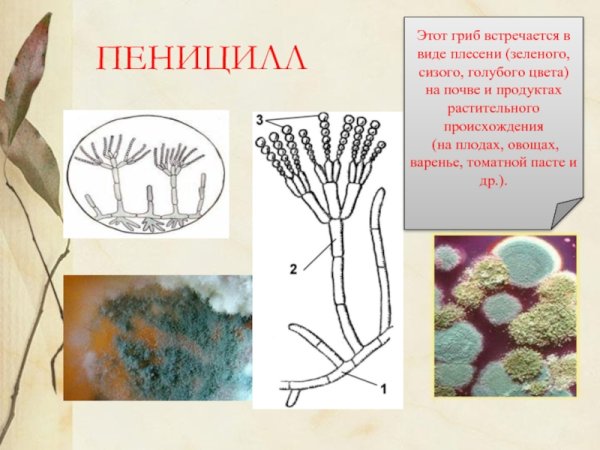
Конидии пеницилла

Рисунок пеницилла - это изображение, которое визуализирует одно из самых известных антибиотиков в мире. Пенициллин был открыт в 1928 году и стал первым антибиотиком, способным бороться с инфекциями, вызванными бактериями. Рисунок пеницилла может быть выполнен в различных стилях и формах, от детализированного и реалистичного до абстрактного и символического. В нем можно увидеть основные черты структуры пенициллина, такие как кольцевая форма и характерные функциональные группы. Этот рисунок может быть интересным и информативным дополнением к научным или медицинским материалам, а также просто представлять эстетическую ценность для людей, интересующихся историей и достижениями в области медицины и науки.
Строение плесневого гриба пенициллина
Строение плесневого гриба пенициллина
Плесневый гриб пеницилл строение
Анаморфа пенициллов
Строение плесневого гриба пеницилла
Конидиеносец пеницилла
Пеницилл строение гриба ЕГЭ
Плесневые грибы пеницилл
Строение плесневого гриба пеницилла
Строение плесневого гриба пеницилла
Конидии пеницилла
Спорангии пеницилла
Строение плесени пеницилл
Пенициллин и мукор
Пеницилл систематика
Гриб пеницилл строение
Пенициллин гриб строение
Строение плесневых грибов пеницилл
Пенициллин гриб строение
Сизая плесень пеницилл
Конидии пеницилла
Мукор пеницилл аспергилл
Плесневелый гриб пеницилл
Penicillium chrysogenum конидиеносцы
Плесневые грибы пеницилл
Гриб пеницилл плесень
Многоклеточные плесневые грибы
Пенициллин строение
Пеницилл строение микробиология
Пеницилл кистевик
Пеницилл группа грибов
Гриб пенициллиум строение
Плесневые грибы пеницилл многоклеточный
Пеницилл строение гриба ЕГЭ
Морфологические признаки грибов мукор
Конидиеносец пеницилла
Гриб пеницилл плесень
Пенициллин гриб строение
Строение мицелия пеницилла
Гриб пеницилл строение
Строение мицелия пеницилла
Строение плесневого гриба мукора рисунок
Гриб пеницилл строение
Гриб пеницилл строение
Penicillium микробиология
Строение грибницы пенициллина
Смотрите онлайн или можете скачать на телефон или компьютер в хорошем качестве совешенно бесплатно. Не забывайте оставить комментарий и посмотреть другие фотографии и изображения высокого качества, например рисунок марала и смена пола рисунки из раздела Рисунки

Grizly.club
Grizly.club